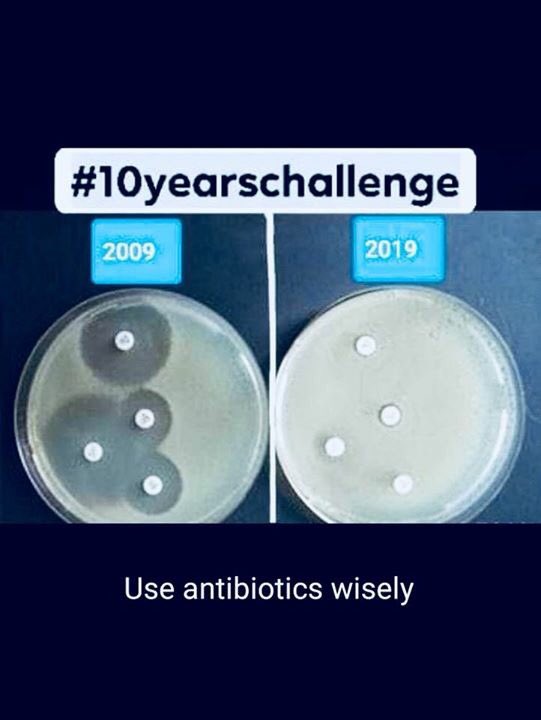
ZaikSpeaks's tweet image. Real #10yearschallenege

#10yearschallenege 搜尋結果
#10yearschallenege zapodzialo się na dysku 😅 najważniejsze, że sobie przypomniałem😏 @BorekMati @TomekHajto7

История одной ЧС: 10 лет назад парень спас двоих детей и рассказывает о том, как это было. #10yearschallenege mchs.gov.by/glavnoe/241012/
2009 : Vacation - Going away from home.! 2019 : Vacation - Coming home.!! #10YearsChallenege
UPDATE: A person named Rahul from @mcdonaldsindia contacted me and helped me out. McDonald's is lou 🖤 #10yearschallenege
Antibiotic resistance is a global threat!#Microbiome modulation in early life might be the key biological mechanism to fight back. #10yearschallenege #binfantis #evivo

İcra daire. dosya sayısı: 2008: 8 milyon 2018: 20 milyon Son 10 yılda artış: %150 Ve Hergün ort. 7.000 icra dosyası açılmakta. 18+ nüfus ~55 milyon ve kabaca her 3 kişiden biri icralık Batık krediler bir önceki yıla göre %44 artışla 90 milyar₺ aştı. Kriz; asla teğet geçmez!



We really really really really really really really really really really really really really really really really really really really recommend you to know that *Happily Married * is a myth ! You can be happy or married ! Really 🔥 #10yearschallenege

دس سال پہلے ہمارے #zakirMajeed کو لاپتہ کیا گیا اور دس سال بعد ہمارے #jeehandBaloch کو لاپتہ کیا گیا۔ #10yearschallenege #EndEnforcedDisappearances




Something went wrong.
Something went wrong.
United States Trends
- 1. Delap 9,018 posts
- 2. Good Saturday 24.2K posts
- 3. Gittens 5,932 posts
- 4. Burnley 29.8K posts
- 5. #askdave N/A
- 6. Neto 17.9K posts
- 7. #SaturdayVibes 3,527 posts
- 8. Tosin 7,640 posts
- 9. #BURCHE 13K posts
- 10. Chalobah 3,670 posts
- 11. #SaturdayMotivation 2,881 posts
- 12. Caturday 4,387 posts
- 13. #LingOrm3rdMeetMacauD1 565K posts
- 14. LINGORM MACAU MEET D1 555K posts
- 15. Maresca 16.7K posts
- 16. Somali 82.8K posts
- 17. IT'S GAMEDAY 1,679 posts
- 18. The View 98.8K posts
- 19. John F. Kennedy 2,552 posts
- 20. Marjorie Taylor Greene 87.1K posts